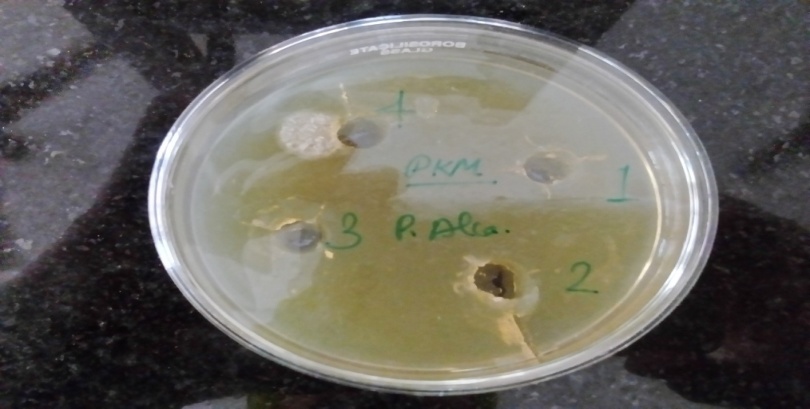
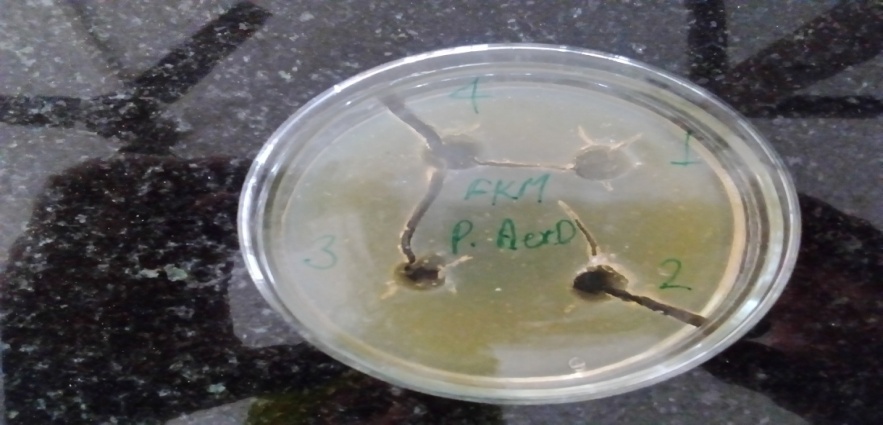
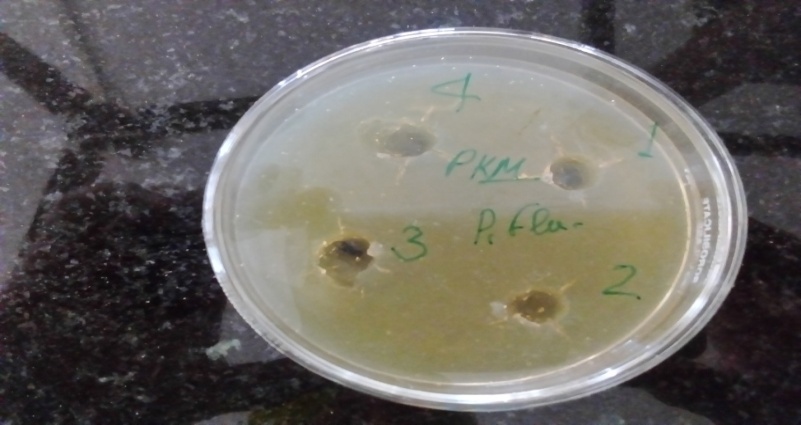

Department of Pharmacology, St. Soldier Institute of Pharmacy, Lidhran Campus, Behind NIT (R. E. C), Jalandhar Amritsar By-Pass NH-1 Jalandhar 144011, Punjab, India
Email: prateekmi888@gmail.com
Received: 11 Sep 2021, Revised and Accepted: 14 Nov 2021
ABSTRACT
Objective: Efficacy of Aqueous and Methanolic Extracts of Plant Brassica Rapa Leaves Potential Anti-Pseudomanal Activity
Methods: Phytochemical analysis of Brassica rapa belonging to the family was examined using Aqueous and Methanolic extracts. Methanolic and aqueous extracts of leaves part of the plant were investigated individually for Anti-pseudomanal activity by agar well diffusion method. The susceptibility of three gram-negative bacteria to the aqueous and Methanolic extracts of this plant was measured and the results compared with standard antibiotic Gentamycin. Both the extracts were tested against selected species of Pseudomonas aeruginosa MTCC2295 (G-ve), Pseudomonas fluorescens MTCC2421 (G-ve), and Pseudomonas alcaligenes MTCC7095 (G-ve), to find the inhibitory activities of microbes at the dose level of 50 and 100 µg/ml.
Results: The phytochemical analysis of Aqueous and Methanolic extracts confirmed the presence of Carbohydrates, Fat, proteins, Vitamins, Minerals, Electrolytes, sugar, soluble and insoluble fiber and amino acids. Methanolic extract of Brassica rapa showed considerably high Anti-pseudomonal activities against all bacteria than Aqueous extract.
Conclusion: The leaves of Brassica Rapa were found to be rich in sulphur and nitrogen-containing compounds. Brassicarapamethanolic extract has anti-pseudomonal effects against bacteria.
The current study's range of activity can provide a new plant source for safe anti-pseudomanal drugs.
Keywords: Brassica rapa, Anti-pseudomanal activities, Agar well diffusion method, Gentamycin, Phytochemical analysis, Turnip green
© 2022 The Authors. Published by Innovare Academic Sciences Pvt Ltd. This is an open access article under the CC BY license (https://creativecommons.org/licenses/by/4.0/)
DOI: https://dx.doi.org/10.22159/ijcpr.2022v14i1.44115 Journal homepage: https://innovareacademics.in/journals/index.php/ijcpr
Medicinal plants are the world's oldest method of healthcare. Throughout history, medicinal plants have been used by all civilizations. According to the World Health Organization (WHO), 80 percent of the world's population now uses herbal medicine for some form of primary health treatment [1, 2]. Medicinal plants are a native legacy of global significance. Natural substance extracts are a valuable source of novel medicines. Plant sections such as stem bark, root bark, aerial branches, vegetative buds, leaves, fruits, and latex were used to treat various illnesses in ancient medicine systems [3]. Current medication includes at least 25% medicines derived from plants, as well as many others that are synthetic drugs based on initial substances extracted from plants [4]. Multiple antibiotic tolerances has already emerged as a result of the indiscriminate usage of commercial antimicrobial medications widely employed in the management of the infectious disease [5]. The treatment of these infections is mainly based on the use of antibiotics; the antibiotics may be associated with adverse effects on the host, including immune suppression, hypersensitivity, and also allergic reactions [6, 7]. However, therapy using antibiotics is going through a crisis due to the development of resistance by pathogens. Staphylococcus aureus is one of the most important pathogens that have become resistant to almost all known antibiotics. Other examples for antibiotic-resistant bacteria are vancomycin-resistant enterococci, multidrug-resistant tuberculosis and others [8]. On the other hand; herbal plant products have got incredible success in serving as a guidepost for new antibacterial drug discovery. According to the World Health Organization, plant extracts or their active constituents are used as folk medicine in traditional therapies of 80% of the world's population [9]. The spectrum of antimicrobial effectiveness of drugs varies greatly. Brassicarapa L. (turnip) is a biennial, outcrossing, mesopolyploid herbaceous plant in the genus Brassica (Cruciferae). Turnip is native to Europe, Russia, Central Asia, and the Middle East, but it is now commonly grown as a vegetable and oil source all over the world [10]. Brassica rapa has historically been used to cure a host of infections, including hepatitis, jaundice, furuncle sore throats, as an antiscorbutic, antiarthritic, resolvent, stimulant, for gastrointestinal complaints, and as a laxative.
Collection and identification of the plant
The leaves part of the plant Brassica rapa was collected from the local dealer of medicinal herbs. This plant was identified and Morphological authenticated by Kuber Impex Limited, Indore, India.
Preparation of plant material
The leaves of plant Brassica rapa were washed properly to remove dirt and powdered well by grinding and avoiding moisture contamination. This powdered material passed through a sieve for obtaining uniform particle size then this powdered crude drug was dissolved in several solutions to determine their optimum solubility.
Aqueous extract
Approximately 100 g. of shade-dried powder of leaves of plant Brassica rapa was taken in a 1 L beaker and chloroform: water (1:99) was added up to a sufficient level to immerse the drug completely. Chloroform was added as a preservative to prevent microbial growth. This setup was placed aside for 72 h. with stirring at alternate intervals. Finally, the contents of the beaker were vacuum filtered to get a clear watery, greenish coloured extract. The extract was concentrated under a high vaccum and completely dried in a desiccator.
Methanolic extract
The leaves of the plant Brassica rapa, were shade-dried and powdered separately. The powder (100 g.) was packed in a soxhlet apparatus and subjected to continuous hot percolation for about 8 h. with methanol (350 ml.) as solvent. The extract was concentrated to a semi-solid mass under vacuum and completely dried in a desiccator.
Preliminary phytochemical analysis
The, Aqueous and Methanolic extracts of leaves of the plant Brassica rapa were subjected to different chemical tests separately for the identification of various active constituents. The tests are as follows [11-13].
Test for alkaloids
Dragendorff's test: 1 ml of Dragendorff's reagent was applied to the extract solution. A reddish-brown precipitate suggests the presence of alkaloids.
Wagner's test: Wagner's reagent (2 ml) was applied to the extract solution.
A reddish-brown precipitate suggests the presence of alkaloids.
Mayer's test: 2 ml of Mayer's reagent was applied to the extract solution.
The presence of alkaloids is shown by a dull white precipitate.
Hager's test: Hager's reagent (3 ml) was applied to the extract solution.
The formation of yellow precipitate confirms the existence of alkaloids.
Tests for steroids
Libermann-Burchard test: In a dry test tube, the extract was dissolved in 2 ml of chloroform.10 drops of acetic anhydride and 2 drops of concentrated sulphuric acid were added. The presence of steroids causes the solution to turn red, then blue, and eventually bluish-grey.
Salkowski test: After dissolving the extract in chloroform, equivalent volumes of concentrated sulphuric acid were applied. The steroid components in the tested extract are represented by the formation of bluish-red to cherry red colour in the chloroform layer and green fluorescence in the acid layer.
Test for flavonoids
Shinoda test: Magnesium ribbons and 1-2 drops of concentrated hydrochloric acid were applied to the extract solution (1 ml). The existence of flavonoids is indicated by the formation of red/pink/green/blue dye.
Pew's test: Zinc (metal) dust was applied to the extract solution, along with a few drops of 5N HCl. The existence of flavonoids is indicated by the development of a red colour.
Test for saponins
Foam test: For 15 min, the test extract was dissolved in distilled water and shaken. Saponins were detected by a one-centimeter layer of foam.
Haemolysis procedure: One drop of blood on a slide was combined with a few drops of test extract; in the presence of saponins, RBCs rupture.
Test for glycosides
Legal test: The extract was dissolved in pyridine, and an alkaline sodium nitroprusside solution was added. The presence of glycosides is indicated by the formation of pink-red to red pigment.
Baljet Test: A 1 ml solution of sodium picrate was applied to a 1 ml solution of extract solution, and the shift in colour from yellow to orange indicates the presence of glycosides.
Test for amino acid
Ninhydrin Test: To the extract solution, two drops of freshly prepared 0.2 percent ninhydrin reagent were applied and heated. The existence of amino acids is revealed by the production of violet colour.
Tests for proteins
Millon's test: The extract solution was combined with Million's reagent, resulting in a white precipitate. Warming causes the precipitate to turn a red brick colour.
Biuret test: Heat the extract solution with a 10% sodium hydroxide solution. Add a few drops of copper sulphate solution after that. The presence of proteins is indicated by the formation of a violet/reddish violet precipitate. The extract solution was combined with concentrated nitric acid for the xanthoproteic examination. The presence of proteins is shown by the formation of a yellow colour that turns orange when alkali is added.
Tests for phenolic compounds
Ferric chloride solution was applied to the extract solution the presence of phenolic compounds is indicated by a product that is dark blue or greenish-black in colour.
Tests for fixed oils
Spot test: A small amount of extract was pressed between two filter sheets the presence of fixed oils is indicated by oil stains on paper.
Tests for carbohydrates
Molisch's test: A few drops of Molisch's reagent were applied to the extract solution (2-3 ml.). When concentrated H2SO4 was added from the test tube's edges, a violet ring formed at the junction of the two liquids, signalling the presence of carbohydrate.
Fehling's test: In a test tube, 1 ml of Fehling's solution A and 1 ml of Fehling's solution B were combined, and an equivalent amount of extract solution was applied. Brick red precipitate was observed after being heated in a boiling water bath for 5-10 min.
Benedict's test: In the test tube, an equal amount of Benedict's reagent was combined with the extract solution and heated in a boiling water bath until the solution turned green, yellow, blue, or red.
Schiff's test: An equal volume of Schiff reagent was applied to the extract solution and shaken for two minutes, and the appearance of pink colour suggested the presence of an aldehydic group.
Tollen's test: Tollen's reagent was applied to the extract solution and heated in a boiling water bath. The presence of carbohydrates was suggested by the formation of a silver mirror.
Anti-microbial screening [14]
Both microorganisms were obtained from the Institute of Microbial Technology (IMTECH), Chandigarh, India, including Pseudomonas aeruginosa MTCC 2295 (G-ve), Pseudomonas fluorescens MTCC 2421 (G-ve), and Pseudomonas alcaligenes MTCC 7095 (G-ve). The media used for microorganism activation followed the MTCC protocol. The Department of Biotechnology (DBT) and the Council of Scientific and Industrial Research (CSIR) of the Government of India jointly finance the Microbial Type Culture Collection and Gene Bank (MTCC), a national facility built-in 1986. The MTCC is a modern facility housed at Chandigarh's Institute of Microbial Technology (IMTECH). It is a member of the World Federation for Culture Collections (WFCC) and has a record with the World Data Centre for Microorganisms (WDCM). The primary goals of this national facility are to serve as a repository, to provide authentic microbial cultures, and to provide relevant services to scientists employed in research institutions, universities, and industries. On 4 October 2002, the World Intellectual Property Organization (WIPO), Geneva, Switzerland, approved the MTCC as an International Depository Authority (IDA), making it the first IDA in India, the seventh in Asia, and the 34th in the world. The deposit of microorganisms under the Budapest Treaty is accepted in 55 member countries as satisfying the necessity of patent procedure. The MTCC currently has five sections: Actinomycetes, Bacteria, Fungi, Yeasts, and Plasmids, with a total of over nine thousand cultures. Cultures are usually preserved using liquid nitrogen and freeze-drying. Mineral oil is sometimes used to protect the fungi. The viability and some main characteristics of the species are tested on a regular basis to ensure that cultures continue to reflect the original deposits. Special properties such as metabolite synthesis and compound degradation are not usually tested. Relevant strain information is computerized for fast search, analysis, and retrieval.
Agar well diffusion method (cup plate/cylinder/pits method)
Autoclaving was used to prepare and sterilize standard glass Petridishes and nutrient agar media. Under aseptic conditions, nutrient agar media was poured into sterilized Petridishes to a depth of 3 to 4 mm. The prepared Petridishes were held in an incubator for 24 h to ensure that no microorganisms grew. Under aseptic conditions, standardized suspensions of selected bacterial strains were distributed on the surface of the Petridish agar media. Using a stainless steel borer with a diameter of about 5 mm, four cups were bored in each Petridish, one for standard antibiotic, one for test sample, one for solvent blank, standard antibiotic (corresponding to microorganisms) and test solutions were serially diluted, 100l of the serially diluted antibiotic solution, test solution, an antibiotic solution, These Petridishes were determined, and the zones of inhibition of the sample were compared to the standard zone of inhibition around the cup. The zones of inhibition of the sample were compared to the standard zone of inhibition of the standard antibiotic used. 100 ml of sterilized 0.9 percent saline was also prepared and sterilized by autoclaving at 15 lbs per 1210c for 15 min. The subcultured organisms slant was shaken with 10 ml saline to achieve an organism suspension. The organism suspension was moved to a sterilized saline solution. The organism was shook into a uniform suspension in the solution. Throughout the experiment, aseptic conditions were maintained in a laminar flow environment. Approximately 0.6 ml of the test organisms' nutrient broth suspensions were applied to 60 ml of sterile nutrient agar that had been cooled to 45°C, blended thoroughly, and poured onto sterile plates. The agar was allowed to solidify before punching six wells (cups) per plate with a sterile cork borer (separate borer for each organism) to ensure proper distribution of wells in the periphery with one well in the middle. The agar plugs were removed, and 50 l test samples of each concentration were pipetted into the corresponding marked wells using micropipettes. Every organism was prepared in triplicate plates. The plates were left at room temperature for 2 h to enable sample diffusion before being incubated face up for 24 h at the corresponding temperatures of each organism. The diameters of the inhibition zones were determined down to the millimeter (the cup size also being included)15.
The percentage yield of both extracts of Brassica rapa was calculated using the formula and shown in table 1. Preliminary Phyto-profile for Brassica rapa is shown in table 2. Phytochemical screening of “Brassica rapa l is shown in table 3.
Table 1: Percentage yield of both extracts of Brassica rapa.
| S. No. | Name of extract | Wt. of powder | Wt. of extract | Percentage yield (w/w) |
| 1. | Aqueous extract | 100 gm | 6.44 gm | 6.44% |
| 2. | Methanolic extract | 100 gm | 5.86 gm | 5.86% |
Table 2: Preliminary phyto-profile for Brassica rapa
| S. No. | Name of extract | Colour | Physical state | Percentage yield (w/w) |
| 1. | Aqueous extract | Brown | Powder | 6.44% |
| 2. | Methanolic extract | Brown | Powder | 5.86% |
Table 3: Phytochemical screening of Brassica rapa l
| S. No. | Test | Observation | Inference |
| Test for organic constituents | |||
| 1 | Test for carbohydrates | ||
|
Violet ring is formed at the junction of two liquids | +ve | |
| 2 | Test for reducing sugars: | ||
|
First yellow then brick red color is observed. | +ve | |
|
Green color is observed. | +ve | |
| 3 | Test for hexose sugars | ||
|
Red color is formed | +ve | |
|
yellow to red color appears | +ve | |
| 4 | Test for non-reducing polysaccharides (starch) | ||
|
Blue color | +ve | |
|
precipitates obtained | +ve | |
| 5 | Test for gums | no red color | -ve |
| 6 | Test for mucilage | no swelling in water | -ve |
| 7 | Test for proteins
|
color change | +ve |
|
color change occur | +ve | |
|
color change occur | +ve | |
|
black, brownish solution | +ve | |
|
ppts. formed | +ve | |
| 8 | Test for amino acids
|
black color | +ve |
|
light brown color | +ve | |
|
white ppts obtained | +ve | |
| 9 | Test for fats and oils | ||
|
no oil globoules appear | -ve | |
|
Insoluble in water | -ve | |
| 10 | Test for volatile oil | Solubility in water | -ve |
| 11 | Test for cardiac glycosides | ||
|
Yellow to orange color | +ve | |
|
Upper layer brown and lower layer bluish color | +ve | |
| 12 | Test for anthra-quinone glycosides | ||
|
Ammonical layer turns pink | +ve | |
| 13 | Test for saponin glycosides | ||
|
Persistent foam is observed | +ve | |
| 14 | Test for coumarin glycosides | aromatic odour | +ve |
| 15 | Test for alkaloids | ||
|
No ppts. | -ve | |
|
No ppts. Obtained No change in solution |
-ve -ve |
|
|
|||
| 16 | Test for tannins and phenolic compounds | ||
|
Deep blue color solution obtained | +ve | |
|
Whiteppts. | +ve | |
|
Whiteppts. | +ve | |
|
Decoloration of bromine water | +ve | |
|
Red color sol. | +ve | |
|
Redppts. | +ve | |
|
Transient red color | +ve | |
|
Reddish to yellow color | +ve | |
|
Decoloration | +ve | |
| 17 | Test for Enzymes | No changes | -ve |
| 18 | Test for organic acid | ||
|
Ppts. were not obtained immediately | +ve | |
| 19 | Test for Vitamins | Pinkish red color appears | +ve |
| Test for inorganic constituents | |||
| 1 | Test for calcium | Whiteppts. | +ve |
| 2 | Test for magnesium | Whiteppts. | +ve |
| 3 | Test for sodium
|
Golden yellow flame | +ve |
| 4 | Test for pottasium | Violet color flame | -ve |
| 5 | Test for iron | Blood red color | +ve |
| 6 | Test for sulphate | White ppts | +ve |
| 7 | Test for phosphate | No crystal | -ve |
| 8 | Test for chloride | Blue color ppts. formed | +ve |
| 9 | Test for carbonate | Whiteppts. | +ve |
| 10 | Test for nitrates | Brown color | +ve |
Antimicrobial activity of Brassica rapa, leaves extracts at the concentrations of 50 mg/ml and 100 mg/ml were tested against all microorganisms, respectively. Standard antibiotic Gentamicin (10 μg/ml) was used against all microorganisms. Minimum concentration that showed inhibition was recorded as the MIC and Antibacterial activity is shown in table 4

Fig. 1: Different petridishes shows the zone of inhibition as well as growth of microorganism # 1=50 mg/ml Aq. Ext. B. R., 2=100 mg/ml Aq. Ext. B. R., 3= standard drug, gentamycin 4=control (without any drug)
Table 4: Antibacterial activity of aqueous and methanol extracts of Brassica rapa
| S. No. | Strain | Extract | Mean diameter of zone of inhibition (in mm) | ||
| 50 mg/ml | 100 mg/ml | Gentamicin (10mcg/ml) | |||
| I | Pseudomonas aeruginosa | Aqueous | 13 | 14 | 27 |
| Methanolic | 16 | 18 | |||
| II | Pseudomonas fluorescens | Aqueous | 14 | 15 | 20 |
| Methanolic | 17 | 18 | |||
| III | Pseudomonas alcaligenes | Aqueous | 12 | 14 | 21 |
| Methanolic | 16 | 18 | |||
a: Inhibition zones are the mean including cup borer (8.5 mm) diameter, b: Standard drug gentamicin (10 μg/ml)

Fig. 2: Antibacterial activity of aqueous extracts of Brassica rapa (SPA = STRAIN Pseudomonas Aeruginosa, SPF = STRAIN Pseudomonas Fluorescens, SPAL = STRAIN Pseudomonas Alcaligenes)

Fig. 3: Different petridishes shows the zone of inhibition as well as growth of microorganism # 1=50 mg/ml Eth. Ext. B. R., 2=100 mg/ml Eth. Ext. B. R., 3= standard drug, Gentamycin 4=control (without any drug

Fig. 4: Antibacterial activity of Methanolicextracts of Brassica rapa (SPA = STRAIN Pseudomonas Aeruginosa, SPF = STRAIN Pseudomonas Fluorescens, SPAL = STRAIN Pseudomonas Alcaligenes)
Antibacterial compounds are well known to exist in higher plants. Plants also inspired new drug compounds, and plant-derived drugs have made significant contributions to human health. Phytomedicine can be used to cure illnesses, as in the Unani and Ayurvedic systems of medicine, or it can be used as the foundation for the formulation of a medicine, a natural blueprint for the development of a drug. The type of solvent used in the extraction process has a significant impact on the subsequent separation of botanical compounds from plant material. Traditional healers mainly use water as a solvent, but we discovered in this analysis that plant extracts extracted with methanol had more consistent antimicrobial activity than those extracted with water. The antibacterial efficacy of the plant Brassica rapa against the tested bacterial strains. In the Kirby-Bauer study, the aqueous extract provided less zones of inhibition than the Methanolic extract. This may be due to the inability of the active constituents to dissolve in aqueous solutions, whereas methanol extract demonstrated some antibacterial activity. More experiments with different polarity solvents will be conducted to investigate the impact of solvent composition on extract efficacy. According to this analysis, Gram negative bacteria are less vulnerable than Gram positive bacteria. Gram positive bacteria, on the other hand, were the most vulnerable. Several studies have found that Gram positive bacteria are more sensitive to plant extracts than Gram negative bacteria. The observed variations are believed to be the product of the doses used in this research.
Anti-pseudomanal active plant principles include soluble fibre minerals, amino acids, isothiocyanate glycosides, essential oil (48 volatile components), 3,3'-di-indolylmethane, sulforaphane, selenium, indole-3-carbinol, Phytol, carotenoids, vitamin C, vitamin E, beta-carotene, manganese, vitamin K, omega-3 fatty acids. Brassica rapa leaves contain high levels of potassium, magnesium, pantothenic acid, vitamin B2, copper, phosphorus, vitamin B1, niacin, and calcium. The essential oil extracted from the leaves of Brassica Rapa was found to be rich in sulphur and nitrogen-containing compounds. Brassica rapamethanolic extract has anti-pseudomonal effects against bacteria. The current study's range of activity can provide a new plant source for safe anti-pseudomanal drugs. Alternatively, if the active theory is present in sufficient concentrations, other constituents can exert antagonistic effects or negate the beneficial effects of the bioactive agents. The most unusual occurrence was shown by a methanol extract of Brassica rapa leaves. This plant may be subjected to more isolation of the therapeutic antimicrobial and pharmacological evaluation.
It’s our privilege to express profound sense of gratitude and cordial thanks to our respected chairman Mr. Anil Chopra, Vice Chairperson Ms. Sangeeta Chopra, St. Soldier Educational Society, Jalandhar for providing the necessary facilities to complete this work.
Nil
All the authors have contributed equally.
There are no conflicts of interest.
Al-Snafi AE. The therapeutic importance of Cassia occidentalis-an overview. Indian J Pharm Sci Res. 2015;5(3):158-71.
Marbin M Ideen, Al-Snafi AE. The probable therapeutic effects of date palm pollens in treatment of male infertility. Tikrit J Pharm Sci. 2008;1(1):30-5.
Goel RK, Singh D, Lagunin A, Poroikov V. PASS-assisted exploration of 1028 new therapeutic potential of natural products. Med Chem Res. 2010;1029.
Nalamolu KR, Nammi S. Antidiabetic and renoprotective effects of the chloroform extract of terminalia chebula retz. seeds in streptozotocin-induced diabetic rats. BMC Complement Altern Med. 2006;6:17. doi: 10.1186/1472-6882-6-17, PMID 16677399.
Service RF. Antibiotics that resist resistance. Science. 1995;270(5237):724-7. doi: 10.1126/science.270.5237.724, PMID 7481757.
Walsh C. Where will new antibiotics come from? Nat Rev Microbiol. 2003;1(1):65-70. doi: 10.1038/nrmicro727, PMID 15040181.
Koehn FE, Carter GT. Tithe evolving role of natural products in drug discovery. Nat Rev Drug Discov. 2005;4(3):206-20. doi: 10.1038/nrd1657.
Ojala T, Remes S, Haansuu P, Vuorela H, Hiltunen R, Haahtela K, Vuorela P. Antimicrobial activity of some coumarin containing herbal plants growing in Finland. J Ethnopharmacol. 2000;73(1-2):299-305. doi: 10.1016/s0378-8741(00)00279-8, PMID 11025169.
Chopra RN, Layer SL, Chopra K. Glossary of Indian medicinal plants. New Delhi: Council of Scientific and Industrial Research; 1956. p. 75.
Sun R. Economic/Academic interest of Brassica rapa. In: Wang X, Kole C, editors, The Brasicarapa genome. Heidelberg, New York, Berlin, London: Springer; 2015. p. 1-16.
Kokate CK. Practical pharmacognosy. Vallabh Prakashan, Delhi, 4th Edition; 1994. p. 107-9.
Vishnoi NK. Advanced practical organic chemistry. 2007 ed. Delhi: Vikas Publishing House Pvt. Ltd, 2nd; 2007. p. 54-5.
Kokate CK, Purohit AP, Gokhale SB. Pharmacognosy, Nirali Prakashan, Pune. 36th ed. Vol. 255; 2006.
http://mtcc.imtech.res.in/aboutmtcc.php. [Last accessed on 05 Aug 2021].
Gunasekaran P. Laboratory Manual in Microbiology, New Age publisher. 1st ed. Vol. 77; 1995.